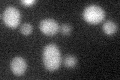
YDL004W
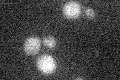
YDL004W

View description
Delta subunit of the central stalk of mitochondrial F1F0 ATP synthase, which is a large, evolutionarily conserved enzyme complex required for ATP synthesis; phosphorylated
Localization:
Intensity:
Fold change:
Significance:
-
C’ GFP library in SD

below threshold15.15 -
N' NOP1pr-GFP in SD

mitochondria140.419 -
N' TEF2pr-mCherry in SD

missing0 -
N' NATIVEpr-GFP in SD

cytosol,punctate22.0445 -
N' TEF2pr-VC and Cyto-VN in SD

#N/A0 -
C’ GFP library in SD+DTT
cytosol15.010.99No -
C’ GFP library in SD+H2O2

cytosol13.010.85No -
C’ GFP library in Starvation Media
cytosol15.551.02No -
C’ GFP library on the background of Pup2-DaMP

below threshold -
C’ GFP library on the background of CCT mutant

below threshold14.24630.940007No
